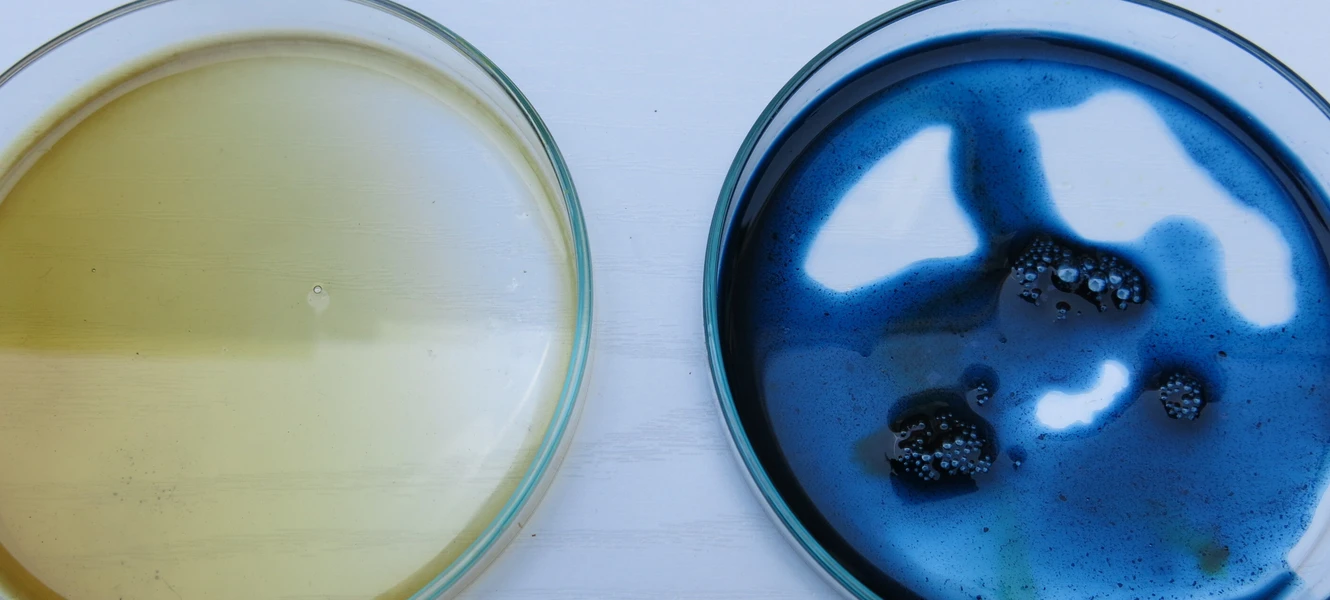

Din urin er fuld af plastik
37 donerede urinprøver fra Eindhoven og et samarbejde med den hollandske kemiker Špela Petric blev startskuddet til Louise Permiins indgående arbejde med at forstå og påvise, hvordan vores eget forbrug af forskellige hverdagsting påvirker kroppen. Helt konkret blander hun urin med forskellige kemikalier og fremkalder en farveskala, der varierer fra gul over til grøn og blå. Den blå illustrerer det højeste indhold af Bisphenol-A (BpA) - et stof, der findes i bl.a. plastikflasker, kasseboner, konservesdåser og legetøj. Selv siger hun:
- Jeg fik et chok første gang, jeg sporede plastik i min egen urin. Da den fine, mørkegule morgenurin langsomt skiftede farve til den smukkeste mørkeblå. Det var en syret oplevelse, som bestod både af en beundring af farvens dybde og samtidig en panik over, hvad dette egentlig betød. Mit tis var fuld af plastik. Det har ligeledes været et stort chok, at stort set alle, jeg har testet, har været BpA-positive.
En installation af urin
Resultatet af de 37 urinprøver blev til installationen Peeing, Processing, Producing, der allerede har været udstillet flere steder i Holland og Danmark, og lige nu turnerer rundt i Tyrkiet med udstillingen WASTE. Baner af urin-indfarvet tekstil, nogle længere end andre, changerende fra næsten hvidt til nuancer af gult, sirligt hængt op på en ramme af træ og med små grøn-blå felter placeret i bunden på hvert stykke. En art tredimensionel graf, der afslører farveforskelle i hver enkelt prøve og nok mest skræmmende af alt påviser BpA i næsten alle indfarvninger.
Med installationen ønsker Louise Permiin at skabe opmærksomhed på vores forbrug af plastik og dets indvirkning på vores kroppe, men også hvor kompleks og omfangsrig hele diskussionen om plastik er. For selvom man kan gøre meget for at vige udenom hormonforstyrrende stoffer som Bisphenol-A, så er det svært helt at undgå det.
- Mikroplast-partikler som BpA filtreres ikke fra på de danske rensningsanlæg, og ryger derfor ud i havene og potentielt tilbage i fisk, vi spiser. Vi bliver cyklisk forbundet med den mad, vi indtager og siden de affaldsstoffer, vi skal af med igen. Der afsættes desværre ikke nok penge til forskning indenfor dette område, hvilket gør det til både et miljømæssigt og et politisk problem, vil jeg mene, siger hun.
Fra kunstværk til ph.d.
Louise Permiin har netop påbegyndt sin ph.d. Embodied Partnerships - for making and managing sensible design places and practices ved Designskolen Kolding. Her tager hun skridtet videre og undersøger, hvordan en sanselig praksis kan skabe forståelse for tekstilindustriens mulige miljøpåvirkninger, og hvordan det kommer til udtryk. Hvor hun med Peeing, Processing, Producing søgte at genfinde en relation og forståelse af vores eget forbrugs påvirkning af kroppen, udvider hun nu paletten til at omfatte alt organisk - både planter, insekter, dyr OG mennesker. Med projektet ønsker hun at eksperimentere med, hvordan disse undersøgelser kan skabe en sammenhængende og håndgribelig kommunikation for fremtidige partnerskaber og bæredygtigt samarbejde mellem designer, produktion og miljøet.
Bisphenol-A
Bisphenol-A (BpA) er en organisk, kemisk forbindelse, der fungerer som byggesten i produktionen af polycarbonatplast (PC) og Epoxyharpikser. Når Bisphenol-A omformes til plast, bliver en lille del tilbage i plasten. Det årlige forbrug af BpA er 3,8 mio tons på verdensplan.
“Mikroplast-partikler som BpA filtreres ikke fra på de danske rensningsanlæg, og ryger derfor ud i havene og potentielt tilbage i fisk, vi spiser. Vi bliver cyklisk forbundet med den mad, vi indtager og siden de affaldsstoffer, vi skal af med igen.- Louise Permiin”